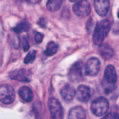
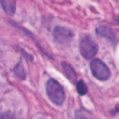
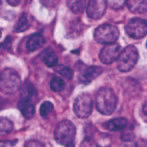

Based on digital whole slide scanning technique, artificial intelligence algorithms represented by deep learning have achieved remarkable results in the field of computational pathology. Compared with other medical images such as Computed Tomography (CT) or Magnetic Resonance Imaging (MRI), pathological images are more difficult to annotate, thus there is an extreme lack of data sets that can be used for supervised learning. In this study, a self-supervised learning (SSL) model, Global Contrast Masked Autoencoders (GCMAE), is proposed, which has the ability to represent both global and local domain-specific features of whole slide image (WSI), as well as excellent cross-data transfer ability. The Camelyon16 and NCTCRC datasets are used to evaluate the performance of our model. When dealing with transfer learning tasks with different data sets, the experimental results show that GCMAE has better linear classification accuracy than MAE, which can reach 81.10% and 89.22% respectively. Our method outperforms the previous state-of-the-art algorithm and even surpass supervised learning (improved by 3.86% on NCTCRC data sets). The source code of this paper is publicly available at https://github.com/StarUniversus/gcmae
翻译:根据数字整体幻灯片扫描技术,深层学习所代表的人工智能算法在计算病理学领域取得了显著成果。与其他医学图像相比,如光学成像(CT)或磁共振成像(MRI),病理图象更难说明,因此极缺乏可用于监督学习的数据集。在这项研究中,提出了一种自我监督的学习模型(SSL),即全球反光遮罩自动算法(GCMAE),它能够代表整个幻灯片图像的全球和地方域特性,以及极好的交叉数据传输能力。Camelyon16和NCETCRC数据集用来评估我们模型的性能。在处理不同数据集的传输学习任务时,实验结果表明,GCMAE的线性分类准确性优于MAE,该模型可分别达到81.10%和89.22%。我们的方法超越了先前的状态-艺术算法,甚至超越了监督性学习能力(在NCCRC/SAR代码源的3.86 %上,可公开查阅的MARC/SALmas。